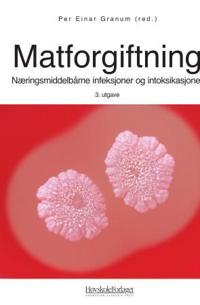
Matforgiftning; næringsmiddelbårne infeksjoner og intoksikasjoner

Pocket
Matforgiftning; næringsmiddelbårne infeksjoner og intoksikasjoner
Beskrivning:
Matforgiftning gir en oversikt over alle næringsmiddelassosierte sykdommer forårsaket av mikroorganismer, og hvordan smittekilder kan identifiseres. Den gir en oversikt over alle de agens som kan medføre slike sykdommer, og forklarer smitteveier og hvordan sykdommene kan forebygges. Boken passer [...]
Visa längre beskrivning
Fakta
- Förlag:
- Høyskoleforl.
- ISBN:
- 9788276346251
- Bandtyp:
- Utgiven:
- 2007
- Språk:
- Norska (bokmål)
- Upplaga:
- 1 (2006)
- Antal Sidor:
- 406
- ISBN-10:
- 8276346251

